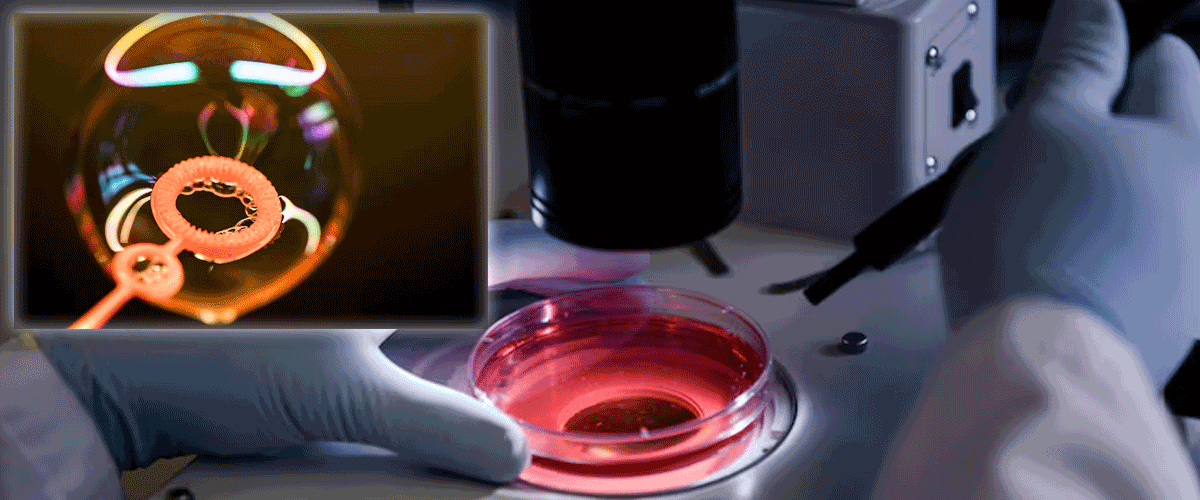
HistoSonics Raises $250 Million to Expand Edison Cancer Treatment Globally

(An Autonomous Body Recognized by Ministry of Commerce & Industry, Government of India)
Competency based placement focussed Education | Training | Research | Consultancy
HistoSonics Raises $250 Million to Expand Edison Cancer Treatment Globally
HistoSonics has secured $250 million in funding to support the commercial and clinical expansion of its Edison histotripsy system, a noninvasive cancer treatment that uses focused sound waves to destroy tumors. The round included investors such as Bezos Expeditions, Thiel Bio, Founders Fund, K5 Global, and Wellington Management, following a recent acquisition of a majority stake that valued the company at $2.25 billion.
The Edison system, which received FDA de novo clearance with backing from Johnson & Johnson, initially targets liver cancers but is being developed for kidney, pancreas, and prostate indications. HistoSonics aims to offer a minimally invasive alternative to surgery, thermal ablation, or radiation, using sound waves to liquefy tumors without cutting or applying heat.
The funds will help HistoSonics expand into international markets, advance ongoing clinical trials, and explore new indications, positioning the company for strategic growth as a privately held entity.
20-10-2025
📰 Recent News
- Medtronic Expands Stealth AXiS System with FDA Clearance for Cranial and ENT Use
- Watchman Device Matches Blood Thinners in Stroke Prevention Trial
- Medtronic Secures CE Mark for Next-Generation Defibrillation Lead
- Philips Gains FDA Clearance for AI-Driven Cardiac Imaging Tool
- Medtronic Secures FDA Approval for Advanced Defibrillation Lead
- GE HealthCare Enters Photon-Counting CT Market with FDA Clearance
- Telesurgery Gains Momentum as SS Innovations and XCath Advance Robotic Care
- Medtronic Expands Pain Portfolio with ViaVerte Distribution Deal
- Samsung Medison Unifies US Imaging Units Under New Brand Identity
- Cerebral Expands ADHD Care with Inflow Acquisition Amid Rising Cases
